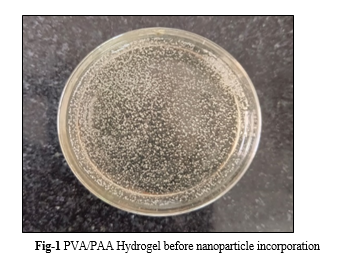

Ijraset Journal For Research in Applied Science and Engineering Technology
- Home / Ijraset
- On This Page
- Abstract
- Introduction
- Conclusion
- References
- Copyright
Green Synthesis of Ag-Ni Bimetallic Nanoparticle-Incorporated PVA/AA Hydrogel with Antimicrobial Properties
Authors: Yuvraj M. Ruparel
DOI Link: https://doi.org/10.22214/ijraset.2023.51810
Certificate: View Certificate
Abstract
In the treatment of burns, inert hydrogels are an essential component of first aid. If there is no access to clean water or if the burns are severe, hydrogel dressings may be used to cool burn wounds instead of running water. Hydrogels that have a high percentage of water content may help to disperse the heat that accumulates on the skin because of their properties. This will not only alleviate the pain, but it will also keep the region clean and guard it from any further damage. The primary objective of current research work is to provide a method for producing bimetallic Ag-Ni nanoparticles using a plant extract as the starting material. After that, these nanoparticles are mixed into a PVA/AA hydrogel that has a property that makes it appropriate for use in medical applications. Because of the antibacterial properties possessed by the nanoparticles found in hydrogel, the two substances working together may be used to hasten the healing process. The PVA/AA medical-grade polymer that was utilised in the creation of the hydrogels does not cause skin irritation and does not cause damage to the natural environment. We used environmentally friendly, one-pot green synthesis approach to synthesise Ag-Ni nanoparticles in a PVA/AA matrix. They function as antibacterial agents that are particularly efficient owing to the size of the particles, which is 12 nm, and their goal is to help in the quick healing of burn wounds and provide protection against E. coli.
Introduction
I. INTRODUCTION
When it comes to the treatment of burn wounds, the use of hydrogel dressings offers distinct benefits to the medical community. Dressings made of hydrogel could absorb wound exudate, which is one of their primary functions. It is entirely conceivable for a hydrogel to possess an absorption capacity that is several hundreds of times greater than its dry weigh [1]. Moreover, the ability of hydrogels to diffuse fluids contributes to the maintenance of a moist environment for wound healing, which is critical for the effective treatment of dry wounds. Hydrogels provide the possibility of achieving this advantageous result. Second, depending on the type of wound that must be treated, hydrogel dressings may be moulded into any specific design that may be required for their treatment. Finally, hydrogel dressings may be able to ease some of the discomfort and warmth associated with the wound while still sticking to it without getting stuck[2]. This would be a significant improvement over traditional dressing. In addition to this, they are transparent, which enables the patient to see the wound that has been created as they are being treated. Research on hydrogel-based burn remedies is developing in a variety of places across the globe, and many discoveries, as well as breakthroughs, have been achieved as a result of this expansion [3-5]. Since the invention of nanotechnology in the previous century, the bulk of development in nanomedicine, also known as the use of nanotechnology in medicine, has taken place over the past three decades [6]. This is also known as the use of nanotechnology in medical. The employment of nanoparticles (NPs) is commonplace across a broad variety of industries, such as the cleaning of drinking water, the manufacture of textiles, the creation of biosensors, and the storage of food. When it comes to the pharmaceutical and medical sectors, the most important role that NPs play is that of an antibacterial agent [7-9]. Antibacterial, antiviral, antifungal, antiangiogenic, antitumor, and antioxidant activities are all possessed by nanoparticles (NPs), in addition to their capacity to combat germs. In the disciplines of imageology and cosmetics, nanoparticles also have the potential to act as a delivery vehicle for various substances[10]. The physicochemical properties of the particles, such as their size, shape, dispersion, and concentration, have the potential to influence the antibacterial efficacy of the substance.
Dermatology is rapidly turning to the use of metal nanoparticles (such as silver, gold, and zinc) because of the positive effects these compounds have on the healing of wounds, as well as the treatment and prevention of bacterial infections[11-15]. The convenience of use, the decrease in the frequency of dressing changes that are necessary, and the preservation of a moist environment surrounding the wound are some additional advantages.
NPs have key characteristics that include their size and shape, which play a role in active substance transport (carrier circulation), penetrability (either directly through cell membranes or via phagocytosis), and cellular responses. Other key characteristics of NPs include their charge, which plays a role in cellular responses. Metal nanoparticles, such as silver, gold, and zinc, are excellent candidates for incorporation into wound dressings due to the antibacterial capabilities they exhibit as well as their low toxicity profiles. Nanoparticles, nanocomposites, coatings, and scaffolds are the four most frequent forms of nanomaterials that are used in the treatment of wounds[16]. Because of the significance that the scientific community places on this subject, a number of review articles that focus on the utilisation of NPs in conjunction with hydrogels have been published in the most recent few years. These articles were published as a result of the significance that the scientific community places on this subject. When nanoparticles (NPs) and hydrogel are mixed together, the hydrogel protects the NPs from being broken down and stops them from clumping together. It also promotes the local dispersion of drugs and exhibits a significant deal of antibacterial activity, both of which benefit in the quick healing of wounds[17]. All these factors contribute to the speedy recovery of wounds. It is possible that the incorporation of green method synthesized NPs into hydrogels will, in a concentration-dependent relationship, result in improvements to the hydrogel's mechanical properties. These benefits may include enhancements to the hydrogel's strength, stiffness, and degradation.
II. MATERIALS AND METHOD
A. Synthesis of PVA/PAA Hydrogel
To produce aqueous Poly vinyl alcohol (PVA), it was dissolved in ultra-pure water at 70 °C while being magnetically agitated. After cooling to room temperature, the mixture was added to a flask with three necks and a condenser. While being magnetically agitated, the required concentrations of acrylic acid (AA) monomer (5 mol% of AA monomer per vinyl alcohol repeating unit) were added to the PVA solution along with the addition of 1000 ppm ammonium persulfate as an initiator. The flask was sealed and set in an oil bath that had been heated to 80 °C after being argon-purged for 30 minutes while swirling the mixed solution. The impact continued for 48 hours after that. The solution was filtered and allowed to sit for the night in order to get rid of the undissolved particles and bubbles. After that, a homogeneous polymer solution was produced.
B. Coconut Coir Extract preparation
The dust was removed from the coconut coir by washing it with deionized water, and then allowing it to dry at room temperature (22–26 °C) for 24 hours before being powdered. An aqueous extract was made by combining 2 gm of powdered leaves with 60 ml of deionized water at a temperature of 70 °C, stirring the mixture continuously for two hours, and then immediately filtering the mixture using Whatman filter paper. Before being used to synthesise NPs, the aqueous extract of coconut coir was kept at a temperature of 4 °C.

C. Synthesis of Bimetallic Ag-Ni Nps in polymer matrix-
The synthesis of Ag-Ni bimetallic nanoparticles was achieved by combining 12.5 ml of 12 mM AgNO3 with 12.5 ml of 9 mM Ni (NO3)3 in a PVA/AA matrix. After that, the tube was stirred while being heated to a temperature of 60 °C. As soon as this temperature was attained, 6 mL of the filtered coconut coir extract was added to the mixture. The mixture was then maintained on a steady stir and heated to 80 °C for one hour. The transformation of the liquid mixture from translucent to light brown served as a monitoring and confirmation mechanism for the creation of the nanoparticles throughout the process.

D. Well diffusion method to test the antimicrobial activity of a compound against E. coli
- Materials: E. coli culture, Nutrient agar, Sterile petri plates, Sterile pipettes, Sterile tips, Sterile water, The test compounds, A sterile cork, borer or a sterile pipette tip, Incubator set at 37°C, Ruler Disinfectant solution.
- Procedure: Sterilize the Petri plates by autoclaving or by exposing them to UV light for at least 30 minutes. Prepare the nutrient agar by following the manufacturer's instructions and pour it into the sterilized petri plates to a depth of 3-4 mm. Allow the agar to solidify completely by leaving it undisturbed for 30-60 minutes at room temperature. Inoculate the agar with E. coli by spreading a loopful of the culture uniformly over the surface of the agar using a sterile loop. Make wells in the agar using a sterile cork borer or a sterile pipette tip. The wells should be of equal size and depth (around 6 mm in diameter and 3 mm in depth) and spaced out evenly. Add the test compound to the well using a sterile pipette. Incubate the plates at 37 °C for 24 hours. After incubation, measure the diameter of the clear zone of inhibition around each well using a ruler. The zone of inhibition is the area around the well where no bacterial growth is observed. Repeat the experiment four times to ensure the accuracy and reproducibility of the results. Calculate the mean diameter of the zone of inhibition and compare it with the control to determine if the test compound has antimicrobial activity against E. coli.
III. RESULTS AND DISCUSSION
A. FT-IR spectra

The C=O stretching band of PAA at 1711 cm-1 was introduced and softly moved towards the lower wave numbers as a result of the addition of PAA to PVA, while the C-O stretching vibration of pure PVA at 1241 cm-1 was progressively strengthened and widened. This demonstrates the formation of a new intermolecular hydrogen bond interaction and verifies that those between PVA and PAA have replaced the PVA hydrogel's hydrogen bond interactions. Also, although the C-O stretching vibration at 1090 cm-1 was somewhat enhanced, the peak of the O-H stretching vibration for the pure PVA membrane, at 3300 cm-1, was progressively expanded and attenuated. This could be brought on by the esterification process between the hydroxyl and carboxylic acid groups in PVA and PAA[18].
B. Swelling Experiments
In addition to measuring polymer film swelling ratios in water and a bicarbonate/phosphate-buffered solution (CBS/PBS, pH 7.4), the dry polymer films were submerged in the liquid for 48 hours prior to being weighed in order for the swelling to become close to equilibrium at room temperature. The free liquid that had gathered on top of the inflated films was then promptly wiped-out using filter paper before the sample weights were once again measured. The abbreviation SR stands for the swelling ratio of the films, and it is described as follows:



Conclusion
In this work, the production of silver-Nickel nanoparticles utilising an extract derived from the bark of coconut coir and incorporated in-situ in hydrogel was reported for the very first time. The extract was used as a reducing agent. The procedure is carried out in a single step, during which the molecules of the extract serve, in the first instance, as reducing agents of Ag+ and, in the subsequent instance, as stabilising agents on produced nanoparticles. Characterization methods suggest that Ag-Ni NPs feature a quasi-spherical shape, with average diameters of 21 nm. The synthetic medical grade hydrogel serves as an effective matrix for the incorporation of silver-Nickel nanoparticles, metal oxide nanoparticles, and silver nanoparticles mixed with metal. Antimicrobial activity assays reveal that Ag-Ni NPs have microbicidal activity on E. coli. In addition, interaction with Ag-Ni NPs results in a significant reduction in the amount of bacterial growth in either strain. Because of its antibacterial and anti-inflammatory effects, the formulation of the hydrogel developed with Ag-Ni NPs shows promise as a therapeutic agent for the healing of burn wounds. These effects allow for a more effective recovery in the burn region. A. Data Availability Statement The raw data supporting the conclusions of this article will be made available by the authors, upon reasonable request. B. Conflict of Interest The authors declare that the research was conducted in the absence of any commercial or financial relationships that could be construed as a potential conflict of interest.
References
[1] Barczak, M.; Borowski, P.; Gila-Vilchez, C.; Alaminos, M.; González-Caballero, F.; López-López, M.T. Revealing importance of particles’ surface functionalization on the properties of magnetic alginate hydrogels. Carbohydr. Polym. 2020, 247, 116747. [2] Chai, Q.; Jiao, Y.; Yu, X. Hydrogels for Biomedical Applications: Their Characteristics and the Mechanisms behind Them. Gels 2017, 3, 6 [3] Fan, D.-Y.; Tian, Y.; Liu, Z.-J. Injectable Hydrogels for Localized Cancer Therapy. Front. Chem. 2019, 7, 675. [4] Li, J.; Mooney, D.J. Designing Hydrogels for Controlled Drug Delivery. Nat. Rev. Mater. 2016, 1, 1–17. [5] Qiu, Y.; Park, K. Environment-sensitive hydrogels for drug delivery. Adv. Drug Deliv. Rev. 2012, 64, 49–60. [6] Akbari, A.; Padervand, M.; Jalilian, E.; Seidi, F. Sodium alginate-halloysite nanotube gel beads as potential delivery system for sunitinib malate anticancer compound. Mater. Lett. 2020, 274, 128038. [7] Drury, J.L.; Mooney, D.J. Hydrogels for tissue engineering: Scaffold design variables and applications. Biomaterials 2003, 24,4337–4351. [8] Geckil, H.; Xu, F.; Zhang, X.; Moon, S.; Demirci, U. Engineering hydrogels as extracellular matrix mimics. Nanomedicine 2010, 5, 469–484. [9] Peppas, N.A.; Hilt, J.Z.; Khademhosseini, A.; Langer, R. Hydrogels in Biology and Medicine: From Molecular Principles to Bionanotechnology. Adv. Mater. 2006, 18, 1345–1360 [10] Li, J.; Wu, C.; Chu, P.K.; Gelinsky, M. 3D printing of hydrogels: Rational design strategies and emerging biomedical applications. Mater. Sci. Eng. R Rep. 2020, 140, 100543. [11] Taneja, H.; Salodkar, S.M.; Parmar, A.S.; Chaudhary, S. Hydrogel based 3D printing: Bio ink for tissue engineering. J. Mol. Liq. 2022, 367, 120390. [12] Advincula, R.C.; Dizon, J.R.C.; Caldona, E.B.; Viers, R.A.; Siacor, F.D.C.; Maalihan, R.D.; Espera, A.H. On the progress of 3D-printed hydrogels for tissue engineering. MRS Commun. 2021, 11, 539–553. [13] Fatimi, A.; Okoro, O.V.; Podstawczyk, D.; Siminska-Stanny, J.; Shavandi, A. Natural Hydrogel-Based Bio-Inks for 3D Bioprinting in Tissue Engineering: A Review. Gels 2022, 8, 179. [14] Huang, J.; Xiong, J.; Wang, D.; Zhang, J.; Yang, L.; Sun, S.; Liang, Y. 3D Bioprinting of Hydrogels for Cartilage Tissue Engineering. Gels 2021, 7, 144 [15] Buenger, D.; Topuz, F.; Groll, J. Hydrogels in sensing applications. Prog. Polym. Sci. 2012, 37, 1678–1719. [ [16] Li, L.; Wang, Y.; Pan, L.; Shi, Y.; Cheng, W.; Shi, Y.; Yu, G. A Nanostructured Conductive Hydrogels-Based Biosensor Platform for Human Metabolite Detection. Nano Lett. 2015, 15, 1146–1151. [17] Ulijn, R.V.; Bibi, N.; Jayawarna, V.; Thornton, P.; Todd, S.J.; Mart, R.; Smith, A.; Gough, J.E. Bioresponsive hydrogels. Mater. Today 2007, 10, 40–48. [18] Dimatteo, R.; Darling, N.J.; Segura, T. In Situ forming injectable hydrogels for drug delivery and wound repair. Adv. Drug Deliv. Rev. 2018, 127, 167–184. [19] Griffin, D.R.; Weaver, W.M.; Scumpia, P.O.; Di Carlo, D.; Segura, T. Accelerated wound healing by injectable microporous gel scaffolds assembled from annealed building blocks. Nat. Mater. 2015, 14, 737–744. [20] Liu, S.; Guo, W. Anti-Biofouling and Healable Materials: Preparation, Mechanisms, and Biomedical Applications. Adv. Funct. Mater. 2018, 28, 1800596.
Copyright
Copyright © 2023 Yuvraj M. Ruparel. This is an open access article distributed under the Creative Commons Attribution License, which permits unrestricted use, distribution, and reproduction in any medium, provided the original work is properly cited.

Download Paper
Paper Id : IJRASET51810
Publish Date : 2023-05-08
ISSN : 2321-9653
Publisher Name : IJRASET
DOI Link : Click Here
 Submit Paper Online
Submit Paper Online

